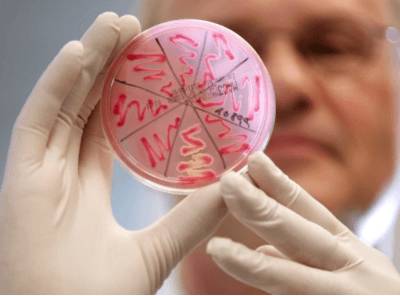

Содержание
При попадании в организм бактерий и вирусов сразу же активизируются защитная система. Иммунитет включается в работу по предотвращению полномасштабного поражения организма патогенными микроорганизмами. Одним из таких веществ, который молниеносно реагирует на наличие чужеродного агента, является С-реактивный белок. С его помощью можно выявить наличие многих заболеваний, начальные стадии которых протекают бессимптомно. Какие показатели нормы содержания этого вещества имеются и как они меняются при наличии различных заболеваний, рассмотрим далее.
Этот вид белка является многокомпонентным, что объясняется его способностью принимать участие в ликвидации патогенных микроорганизмов. Состоит он из протеинов и углеводов, постоянно обновляясь. Синтез С-реактивного белка осуществляется клетками печени. Данный процесс является непрерывным, поэтому даже при отсутствии угрозы для организма его выработка продолжается.
В случае, когда в организм попадает микроб, посредствам сигнализации головным мозгом, печень получает команду на усиленную выработку данных веществ.

Анализ по выявлению СРБ в крови помогает выявить острое течение многих недугов более точно, нежели СОЭ. Дело в том, что скорость оседания эритроцитов увеличивается прямопропорционально наличию воспалительного процесса, в то время, как появление реактивного белка происходит в первые 3-4 часа после инфицирования. Соответственно такая диагностика будет более достоверной и точной.
С помощью данного анализа можно предотвратить обширные воспалительные процессы, а также не допустить усугубления состояния человека.
Какие значения считать нормальными?
В последнее десятилетие лаборатории способны определять два показателя СРБ: общее и базовое значение. Первый показатель показывает суммарное количество белка в мг, определяемое на 1 литр крови. Базовое значение является относительным. Оно помогает оценить, насколько человек, не страдающий острыми воспалительными заболеваниями, подвержен заболеваниям сердечно-сосудистой системы.
Общепринятой нормой СРБ у детей, мужчин и женщин является показатель, не превышающий 5 мг/л. У здоровых людей анализ крови может показать отрицательный результат, так как во время отсутствия острой воспалительной реакции синтез данного белка осуществляется в незначительных количествах.
Базовый показатель, указывающий на подверженность развития сердечно-сосудистых заболеваний, возникающих в результате увеличения количества вредного холестерина, в норме не должен превышать 1 мг/л.
Для отдельных категорий пациентов показатели нормы могут незначительно отличаться. Для новорожденных и детей первой недели жизни допустимо значение реактивного белка до 15 мг/л крови, что объясняется естественными защитными свойствами организма и становлением иммунитета.
В период беременности показатели не должны превышать 7-10 мг/л.
А вот в пожилом возрасте, когда иммунитет угасает под воздействием естественных процессов старения, С-реактивный белок не превышает 3,4-4 мг/л.
Врачи подчеркивают важность определения уровня С-реактивного белка (СРБ) для диагностики воспалительных процессов в организме. СРБ является маркером воспаления, и его уровень может значительно повышаться при различных заболеваниях, таких как инфекции, аутоиммунные расстройства и даже некоторые виды рака. Нормальные значения СРБ варьируются в зависимости от лаборатории, но обычно не превышают 5 мг/л. Врачи отмечают, что повышение этого показателя может указывать на активное воспаление, что требует дальнейшего обследования и анализа. Однако важно помнить, что СРБ не является специфичным маркером, и его интерпретация должна проводиться в контексте других клинических данных. Регулярные проверки уровня СРБ могут помочь в мониторинге состояния здоровья и эффективности лечения.

Возможен ли ложный результат?
Современные методы исследования сводят к минимуму погрешность при выявлении С-реактивного белка, поэтому вероятность получения ложного результата ничтожно мала. Погрешность увеличивается при отсутствии подготовки к исследованию, а также при наличии хронических заболеваний.
Правильная подготовка к анализу
Специфической подготовки к сдаче крови не требуется. Достаточно соблюдать следующие рекомендации:
- Сдавать кровь натощак в первые часы после пробуждения.
- Отказаться от алкоголя и табакокурения за 12 часов.
- Избегать стрессов и хорошо выспаться накануне.
За 2-3 дня необходимо ограничить любые физические нагрузки, особенно те, которые связаны со спортом.
Чрезмерная выработка протеина, участвующего в росте мышечного волокна, может давать ложноположительный результат.
Посмотрите полезное видео
Узнавая нормы С-реактивного белка (СРБ), многие люди обращают внимание на его значение в диагностике воспалительных процессов. СРБ — это белок, уровень которого в крови повышается при воспалении, инфекциях и некоторых хронических заболеваниях. Важно понимать, что нормальные значения могут варьироваться в зависимости от лаборатории, но обычно они находятся в пределах 0-5 мг/л.
Медики подчеркивают, что высокий уровень СРБ может свидетельствовать о наличии серьезных заболеваний, таких как ревматоидный артрит или сердечно-сосудистые болезни. Однако не стоит забывать, что результаты анализа следует интерпретировать в комплексе с другими исследованиями и симптомами. Многие пациенты отмечают, что регулярное обследование и контроль уровня СРБ помогают им лучше понимать свое здоровье и принимать обоснованные решения о лечении.

Особенности показателей при онкологии, остеопорозе и ревматизме

Такие выводы помогает сделать тот факт, что для подавления воспалительного процесса, который возникает в ответ на наличие патогенных микроорганизмов, используется большое количество различных микроэлементов, в том числе и ионов кальция.
Если человек имеет хронические заболевания, которые сопровождаются воспалительными процессами, то со временем запасы кальция исчерпываются.
После расходования всех ионов кальция, имеющихся в свободном доступе, организм начинает тратить накопленные ресурсы, хранящиеся в депо.
Таким депо выступают кости. Постепенный захват ионов кальция из костной ткани и отсутствие процесса замещения способствует стремительному распространению рыхлости костной ткани. В результате развивается остеопороз, истинная причина которого может быть связана непосредственно с ответной иммунной реакцией на наличие воспалительного процесса.
Научно зафиксированных цифровых значений, которые являются порогом при развитии остеопороза, не установлено. Однако доказано, что при длительном течении воспаления и высоких показателях СРБ риски развития данного недуга увеличивается в десятки раз.
Ревматоидный фактор включает исследование на С-реактивный белок, так как высокие его значения может указывать на стремительное увеличение и распространение воспалительного процесса по всему организму. Данное исследование при ревматизме помогает проследить динамику заболевания, а также выявить наличие недуга на ранней стадии, что позволит правильно подобрать лечение.
С-реактивный белок при наличии ревматоидного артрита может длительное время показывать стабильно высокие значения, которые могут доходить до 80-100 мг/л при обострении.
Наличие онкологических заболеваний подразумевает присутствие в организме воспалительного процесса в вялотекущей форме. Анализ крови СРБ, показывающий незначительное увеличение данного показателя, которое сохраняется достаточно длительное время, может указывать на наличие онкологического заболевания.
С-реактивный белок при наличии онкологии может находиться на высоком уровне, при этом внешне никаких клинических проявлений не будет проявляться. Такой маркер помогает выявить наличие заболевания на ранних стадиях, поэтому он включен в биохимический анализ крови.
Повышенные значения
Статистика показывает, что различные заболевания способны вызывать различные колебания уровня белка в крови. Такая взаимозависимость помогает врачам заподозрить наличие того или иного заболевания, основываясь на полученных цифрах. Однако, стоит понимать, что этот показатель крайне относительный и не всегда может с точностью указывать на наличие того или иного недуга.
Поэтому важно учитывать и такие параметры пациента, как возраст, пол и наличие хронических заболеваний.
Показатели белка, которые находятся в рамках 25-50 мг/л, характерны для вирусного заболевания. Так может проявляться грипп, герпес, кишечный грипп, рото-вирус и адено-вирус. В данном случае ответная реакция организма развивается медленнее, так же как и симптоматика.
Когда биохимический анализ крови показывает показатели в 15-20 мг/л крови, и они способны держаться достаточно длительное время без увеличения, речь может идти о наличии онкологических заболеваний или аутоиммунных процессах. Как показывает практика, данные показатели являются наиболее опасными для организма, так как перечень возможных патологий, развивающихся при незначительных отклонениях от нормы, велик.
При диагностике того или иного заболевания, для которого характерно увеличение С-реактивного белка в крови, необходимо сопоставлять полученные данные с особенностями пациента. К примеру, при наличии 100 мг/л белка у мужчины после 55 лет и ребенка дошкольного возраста, причины могут кардинально отличаться. Мужчина вряд ли при таких показателях будет болен детскими инфекциями, свойственными только детям. В то время, как ребенок вряд ли может иметь проблемы с высокими концентрациями холестерина в крови и атеросклерозом, что более свойственно людям средних лет.
Поэтому уместно рассмотреть все возможные причины высоких показателей для разных категорий пациентов.

Высокие показатели у женщин
Выделяют три категории заболеваний, которые могут провоцировать увеличение показателей белка в крови:
- Гинекологические заболевания – чаще всего так проявляется эрозия шейки матки, воспалительные процессы влагалища, полости матки и придатков. Обычно высокие показатели сочленяются с характерными клиническими признаками, которые подсказывают врачу направление в диагностике.
- Заболевания мочеполовой системы – сюда входит, цистит, пиелонефрит, микоплазмоз, хламидиоз и другие инфекции, провоцирующие воспаление мочеполовой системы. В данном случае характерно появление самых высоких показателей, так как воспаление протекает в острой форме. Скрытое течение хронических недугов провоцирует незначительное отклонение от нормы.
- Онкологические заболевания – именно рак груди и рак шейки матки длительное время могут протекать бессимптомно, что увеличивает риски. Для онкологии характерно незначительное отклонение от нормы в показателях белка, однако данные значения сохраняются длительное время.
В случае, когда норма у женщин белка превышена, первым делом врач дает направление на осмотр гинеколога.
С помощью сбора подробного анамнеза и современных методов исследований можно правильно и своевременно поставить диагноз и подобрать соответствующее лечение.
С-реактивный белок при наличии беременности может иметь некоторые отклонения, которые являются нормой и связаны с гормональной перестройкой в организме.
Причины повышения у детей
Для детского организма, который не имеет достаточного иммунитета, угрозой являются вирусы и бактерии, которые могут попасть в организм вместе с водой, едой и воздухом. Поэтому, первым делом, когда проявляется высокий С-реактивный белок в крови у детей, необходимо исключить наличие воспалительного процесса.
В детском возрасте чаще всего могут встречаться такие заболевания, как:
- ангина;
- бронхит;
- пневмония;
- гастрит;
- сальмонеллез;
- ОРЗ и ОРВИ.
На втором месте стоят паразитарные инфекции, вызванные попаданием в организм различных паразитов, способных длительное время жить в пищеварительном тракте или крови.
Сюда относят:
- лямблия;
- аскариды;
- бычий цепень;
- лентец.
Диагностика заболевания должна полностью исключить наличие вышеуказанных недугов в детском организме. Только после их отсутствия можно переходить к более детальной диагностике нехарактерных заболеваний для детского возраста.
С-реактивный белок с высоким значением у новорожденного может указывать на сепсис, образовавшийся в процессе родоразрешения.
Или же данный процесс может быть причиной активизации естественных защитных свойств.
Высокие показатели у мужчин
Для мужчин характерно наличие хронических заболеваний, которые вызваны неправильным образом жизни, а также присутствием вредных привычек. Вредные условия работы и малоподвижный образ жизни также дают о себе знать. Стоит напомнить, что мужчины при наличии различного рода симптоматики предпочитают принять обезболивающее лекарство, нежели отправиться на консультацию к врачу и найти истинную причину происходящего. В свою очередь это провоцирует высокие показатели развития хронических недугов и смертность в среднем возрасте.

- хронические заболевания дыхательных путей: пневмония, бронхит, силикоз, силикотуберкулез;
- язва и гастрит;
- холецистит;
- панкреатит;
- язвенный колит;
- мочекаменная болезнь;
- половые инфекции;
- простатит;
- наличие новообразований в половых органах и простате.
Как показывает статистика, проявление онкологии на ранних стадиях у мужчин можно выявить только при наличии отклонений С-реактивного белка от нормы.
Каких-либо болевых и дискомфортных ощущений нет.
Высокие значения у пациентов пожилого возраста
После 55 лет, когда организм подвержен ускоренным процессам старения, С-реактивный белок в норме имеет минимальные показатели. Это связано с особенностями иммунной системы, которая постепенно угасает на фоне изменения гормонального фона. Чаще всего высокие значения могут указывать на наличие обострения течения хронического заболевания, которых к старческому возрасту немало. Диагностика причины производится с учетом анамнеза, а также внешних клинических проявлений.

Анализ крови на СРБ, расшифровка которого показывает высокие значения, не стоит игнорировать даже при наличии хорошего самочувствия. Некоторые воспалительные процессы в организме могут протекать в скрытой форме, а первые симптомы проявлять, когда площадь поражения становится большой.
Поэтому, если данные анализа показали отклонения от нормы, требуется комплексная диагностика.
Пониженные значения
Рассмотрим два варианта развития событий, когда С-реактивный белок находится в норме или же его выявить в крови не удалось. В первом случае, когда человек чувствует себя хорошо и не имеет жалоб на здоровье, а биохимический анализ крови показывает критически малые концентрации белка, значит, человек полностью здоров и в организме нет воспалительных процессов. Низкие показатели указывают на то, что нет необходимости усиленного синтеза клетками печени белка, что может указывать на состояние полного здоровья.
Во втором случае, когда у человека имеются явные клинические признаки наличия заболевания (высокая температура, плохое самочувствие), но при этом показатели белка ничтожно малы, можно заподозрить наличие проблем с иммунитетом, а также печенью. Ряд аутоиммунных процессов может провоцировать подавление синтеза белка, что не позволяет его обнаружить даже при наличии острого течения заболевания.
Поэтому невозможно правильно поставить диагноз, основываясь лишь на показателях С-реактивного белка.
Этот маркер является лишь незначительной подсказкой в определении того или иного недуга.
Профилактика нормального уровня
Поскольку белок является реакцией организма на патоген, то предотвратить его появление в крови можно, если придерживаться рекомендаций, которые способствуют профилактике заболеваний:
- Пить только очищенную воду, избегая колодцев и ручьев.
- Использовать только качественные продукты питания, избегая полуфабрикатов.
- Мясо-молочные продукты следует в обязательном порядке подвергать тепловой обработке, дабы снизить вероятность инфицирования паразитами.
- Рыбу необходимо готовить не менее 50 минут, а в сыром виде лучше не употреблять.
- Перед едой обязательно мыть руки.
- В межсезонье принимать комплексные витамины, которые позволят укрепить иммунитет и снизить риски инфицирования.
- Ограничить контакты с больными людьми, а также потенциальными носителями возбудителей заболеваний.
- Пить достаточное количество жидкости в день, что поможет максимально быстро вывести патоген из организма.
- Поддерживать оптимальные микроклиматические условия в жилом помещении.
- При контакте с животными обязательно мыть руки с мылом и ежегодно обследоваться на наличие глистных инвазий.
- Лечить заболевание своевременно, не допуская его перехода в хроническую форму.
- Ежегодно проходить плановый медосмотр.
Поскольку этот белок может выступать показателем при онкологических заболеваниях, не стоит игнорировать его показатели.
Количество белковых молекул, превышающих норму, в большинстве случаев указывает на наличие воспалительного процесса.
Таким образом, количество реактивного белка в крови у женщин, мужчин и детей может изменяться по различным причинам, характерным только для определенного возраста. Но не всегда это правило работает. Поэтому не стоит возлагать все надежды именно на этот показатель. Он является только подсказкой, но более точный диагноз без дополнительных методов исследования поставить невозможно. Даже незначительные отклонения от нормы могут указывать на наличие какого-либо заболевания, поэтому от дополнительной диагностики отказываться не стоит.
Вопрос-ответ
Что такое С-реактивный белок и зачем он нужен?
С-реактивный белок (СРБ) — это белок, который вырабатывается печенью в ответ на воспаление в организме. Он является маркером воспалительных процессов и может помочь в диагностике различных заболеваний, таких как инфекции, аутоиммунные расстройства и сердечно-сосудистые заболевания.
Каковы нормы уровня С-реактивного белка в крови?
Нормальные значения С-реактивного белка в крови обычно составляют менее 10 мг/л. Однако точные нормы могут варьироваться в зависимости от лаборатории и метода тестирования, поэтому всегда стоит консультироваться с врачом для интерпретации результатов.
Как подготовиться к анализу на С-реактивный белок?
Для анализа на С-реактивный белок специальная подготовка не требуется. Однако рекомендуется сдавать кровь натощак, чтобы получить более точные результаты. Также стоит сообщить врачу о принимаемых лекарствах, так как некоторые из них могут повлиять на уровень СРБ.
Советы
СОВЕТ №1
Перед сдачей анализа на уровень С-реактивного белка (СРБ) рекомендуется проконсультироваться с врачом. Он поможет определить необходимость теста и объяснит, как правильно подготовиться к нему, чтобы результаты были максимально точными.
СОВЕТ №2
Обратите внимание на факторы, которые могут повлиять на уровень СРБ, такие как инфекции, воспалительные заболевания или травмы. Если вы испытываете симптомы, такие как лихорадка или боль, сообщите об этом врачу перед сдачей анализа.
СОВЕТ №3
После получения результатов анализа важно не спешить с выводами. Уровень СРБ может варьироваться в зависимости от различных факторов, поэтому обсудите результаты с врачом, чтобы понять, что они значат в контексте вашего здоровья.
СОВЕТ №4
Регулярно проверяйте уровень С-реактивного белка, если у вас есть хронические заболевания или факторы риска. Это поможет отслеживать воспалительные процессы в организме и своевременно принимать меры для их контроля.



